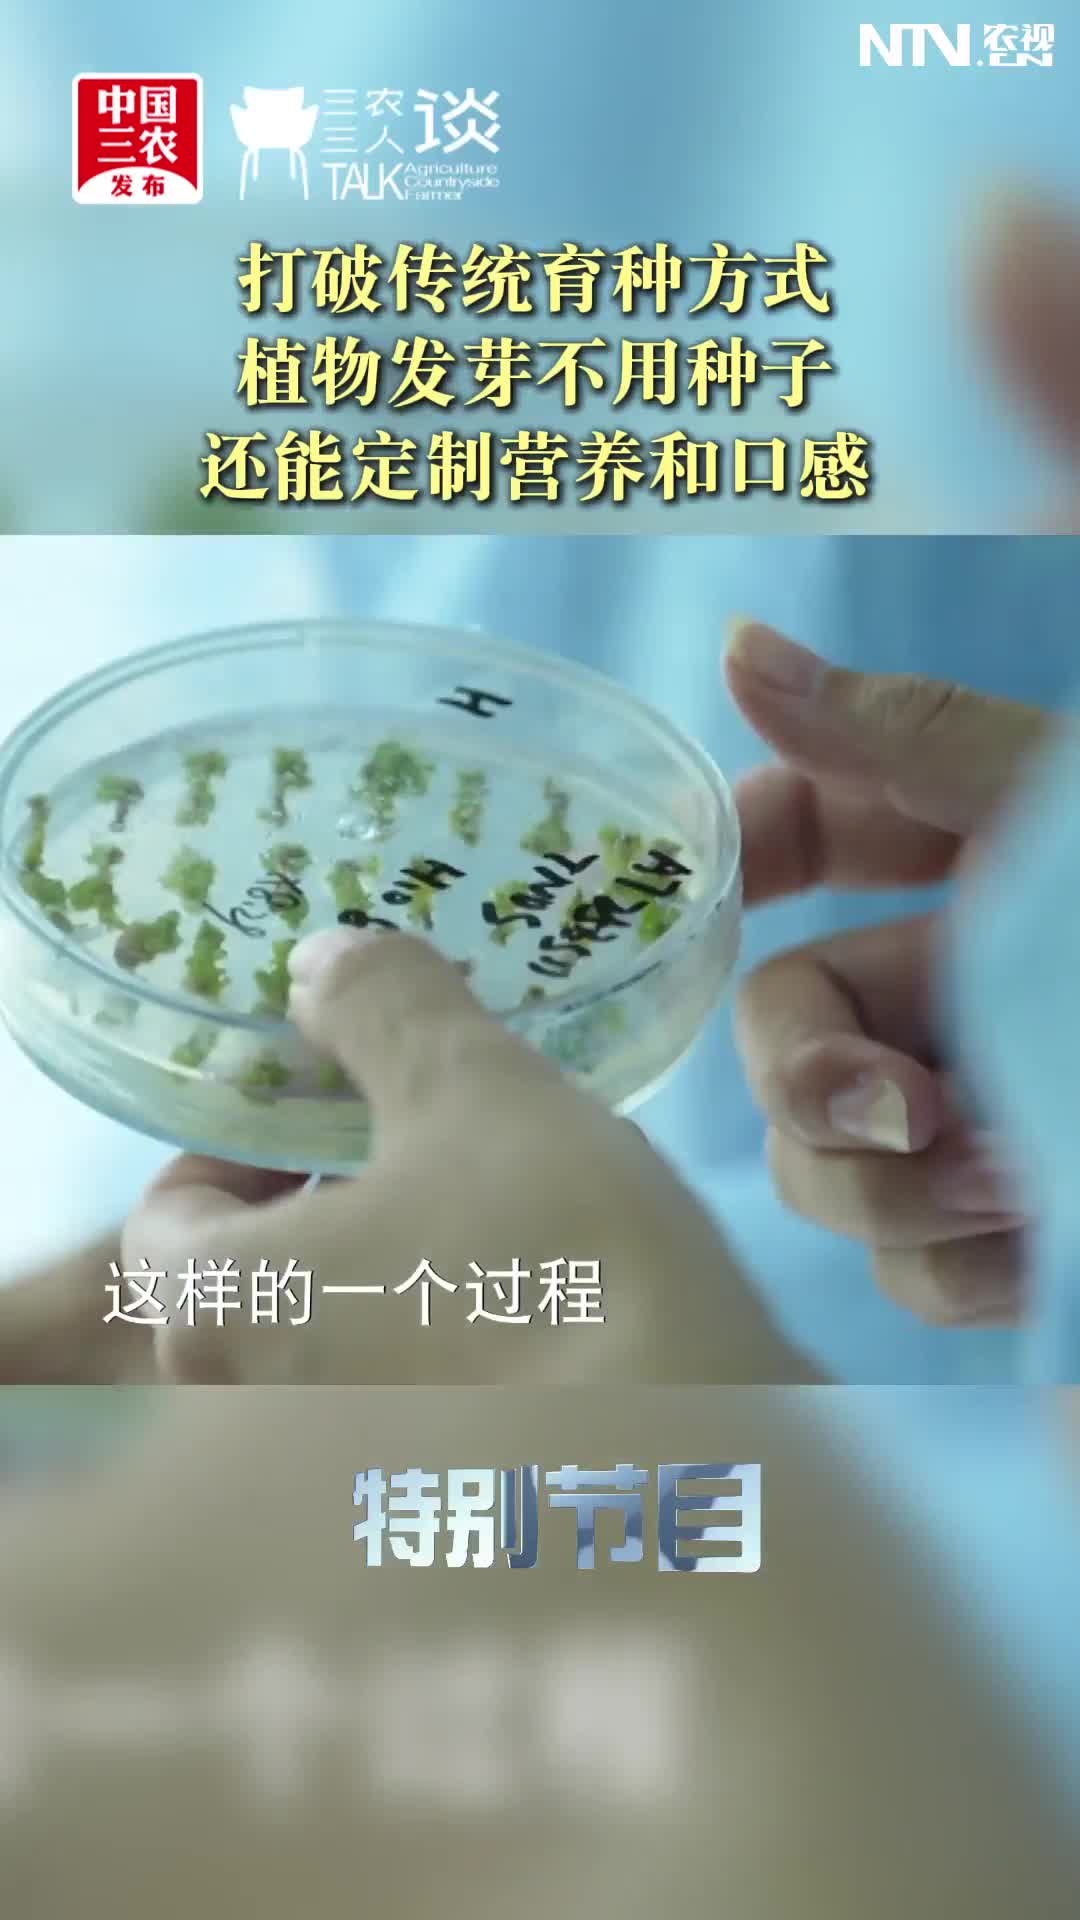

整期節(jié)目
-
 三田鼠大嬸:做一朵“心不甘的花”
2025-11-13
三田鼠大嬸:做一朵“心不甘的花”
2025-11-13 -
 “大衣哥”遭網(wǎng)暴案今日宣判:朱之文勝訴 網(wǎng)暴者被判處6個(gè)月刑期
2025-11-02
“大衣哥”遭網(wǎng)暴案今日宣判:朱之文勝訴 網(wǎng)暴者被判處6個(gè)月刑期
2025-11-02 -
 關(guān)注豬肉價(jià)格下行背后的市場(chǎng)調(diào)節(jié)
2025-10-28
關(guān)注豬肉價(jià)格下行背后的市場(chǎng)調(diào)節(jié)
2025-10-28 -
 把山坡地打造成萬(wàn)元田 一塊紅薯帶動(dòng)162個(gè)山村增收致富
2025-10-22
把山坡地打造成萬(wàn)元田 一塊紅薯帶動(dòng)162個(gè)山村增收致富
2025-10-22 -
 從“菊黃蟹肥”到“全年蟹肥” 這家公司的參賽項(xiàng)目有點(diǎn)貨
2025-10-22
從“菊黃蟹肥”到“全年蟹肥” 這家公司的參賽項(xiàng)目有點(diǎn)貨
2025-10-22 -
 這批小伙伴把傳統(tǒng)“三農(nóng)”工作“秀”出了“年輕態(tài)”“科技范”
2025-10-22
這批小伙伴把傳統(tǒng)“三農(nóng)”工作“秀”出了“年輕態(tài)”“科技范”
2025-10-22 -
 《我把豐收獻(xiàn)祖國(guó)》:肥了黑土地 富了咱農(nóng)民
2025-10-22
《我把豐收獻(xiàn)祖國(guó)》:肥了黑土地 富了咱農(nóng)民
2025-10-22 -
 連陰雨對(duì)小麥播種有何影響?農(nóng)民朋友切記“寧晚勿濫”!
2025-10-22
連陰雨對(duì)小麥播種有何影響?農(nóng)民朋友切記“寧晚勿濫”!
2025-10-22 -
 小麥抗?jié)裢聿リP(guān)鍵4招!更換品種 適當(dāng)增加播量 適當(dāng)淺播 增加底肥
2025-10-22
小麥抗?jié)裢聿リP(guān)鍵4招!更換品種 適當(dāng)增加播量 適當(dāng)淺播 增加底肥
2025-10-22 -
 我把豐收獻(xiàn)給祖國(guó):“綠色寶石”掛滿枝,村富民豐笑開顏
2025-10-03
我把豐收獻(xiàn)給祖國(guó):“綠色寶石”掛滿枝,村富民豐笑開顏
2025-10-03 -
 浙江青田:一地雙收 稻香魚肥
2025-10-02
浙江青田:一地雙收 稻香魚肥
2025-10-02 -
 奶粉依然是長(zhǎng)輩和寶寶的心頭好
2025-09-25
奶粉依然是長(zhǎng)輩和寶寶的心頭好
2025-09-25 -
 奶農(nóng)迎來(lái)春天 修訂后的滅菌乳標(biāo)準(zhǔn)實(shí)施倒逼行業(yè)“鮮”人一步
2025-09-25
奶農(nóng)迎來(lái)春天 修訂后的滅菌乳標(biāo)準(zhǔn)實(shí)施倒逼行業(yè)“鮮”人一步
2025-09-25 -
 買牛奶不用再糾結(jié)配料表 修訂后的滅菌乳標(biāo)準(zhǔn)實(shí)施一周 奶市量足價(jià)穩(wěn)
2025-09-25
買牛奶不用再糾結(jié)配料表 修訂后的滅菌乳標(biāo)準(zhǔn)實(shí)施一周 奶市量足價(jià)穩(wěn)
2025-09-25 -
 三農(nóng)深鏡頭 | 尋找馴鹿
2025-09-08
三農(nóng)深鏡頭 | 尋找馴鹿
2025-09-08
短視頻
-
 南瓜番茄秸稈別浪費(fèi)!揉絲發(fā)酵變牛羊飼料 營(yíng)養(yǎng)比玉米秸稈還高
2025-11-07
南瓜番茄秸稈別浪費(fèi)!揉絲發(fā)酵變牛羊飼料 營(yíng)養(yǎng)比玉米秸稈還高
2025-11-07 -
打破傳統(tǒng)育種方式 植物發(fā)芽不用種子 還能定制營(yíng)養(yǎng)和口感
2025-11-07
打破傳統(tǒng)育種方式 植物發(fā)芽不用種子 還能定制營(yíng)養(yǎng)和口感
2025-11-07 -
 數(shù)字灌溉:萬(wàn)里之外 手機(jī)一鍵開啟澆水施肥
2025-11-07
數(shù)字灌溉:萬(wàn)里之外 手機(jī)一鍵開啟澆水施肥
2025-11-07 -
 劃重點(diǎn)!“十五五”規(guī)劃建議:夯實(shí)基礎(chǔ) 全面發(fā)力的關(guān)鍵時(shí)期!
2025-10-30
劃重點(diǎn)!“十五五”規(guī)劃建議:夯實(shí)基礎(chǔ) 全面發(fā)力的關(guān)鍵時(shí)期!
2025-10-30 -
 關(guān)注豬肉價(jià)格下行背后的市場(chǎng)調(diào)節(jié)
2025-10-30
關(guān)注豬肉價(jià)格下行背后的市場(chǎng)調(diào)節(jié)
2025-10-30 -
 山東省招遠(yuǎn)市大戶陳家村:文明鄉(xiāng)風(fēng)浸潤(rùn)美麗鄉(xiāng)村,精神富足助推鄉(xiāng)村振興
2025-10-30
山東省招遠(yuǎn)市大戶陳家村:文明鄉(xiāng)風(fēng)浸潤(rùn)美麗鄉(xiāng)村,精神富足助推鄉(xiāng)村振興
2025-10-30 -
 菌草專家林占熺:用菌草替代50%的青貯玉米 可為寧夏節(jié)約60萬(wàn)畝耕地
2025-08-18
菌草專家林占熺:用菌草替代50%的青貯玉米 可為寧夏節(jié)約60萬(wàn)畝耕地
2025-08-18 -
 巨菌草可在沙漠 鹽堿地種植 種植戶每畝可收入7000多元
2025-08-18
巨菌草可在沙漠 鹽堿地種植 種植戶每畝可收入7000多元
2025-08-18 -
 寧夏閩寧鎮(zhèn):農(nóng)戶工資性收入一半以上來(lái)源于葡萄酒產(chǎn)業(yè)
2025-08-18
寧夏閩寧鎮(zhèn):農(nóng)戶工資性收入一半以上來(lái)源于葡萄酒產(chǎn)業(yè)
2025-08-18 -
 員工上班可帶娃 閩寧協(xié)作企業(yè)為打工婦女姐妹解決后顧之憂
2025-08-18
員工上班可帶娃 閩寧協(xié)作企業(yè)為打工婦女姐妹解決后顧之憂
2025-08-18 -
 兩山直播預(yù)告:8月15日下午3點(diǎn),鎖定中國(guó)三農(nóng)發(fā)布、農(nóng)民日?qǐng)?bào)、農(nóng)視網(wǎng)、三農(nóng)頭條 全矩陣直播間
2025-08-12
兩山直播預(yù)告:8月15日下午3點(diǎn),鎖定中國(guó)三農(nóng)發(fā)布、農(nóng)民日?qǐng)?bào)、農(nóng)視網(wǎng)、三農(nóng)頭條 全矩陣直播間
2025-08-12 -
 黃土高原上的蘋果情#解讀?安百姓的幸福密碼 #習(xí)語(yǔ)回響
2025-08-11
黃土高原上的蘋果情#解讀?安百姓的幸福密碼 #習(xí)語(yǔ)回響
2025-08-11 -
 立秋 與暴雨不期而遇,萬(wàn)物執(zhí)著生長(zhǎng)#二十四節(jié)氣
2025-08-07
立秋 與暴雨不期而遇,萬(wàn)物執(zhí)著生長(zhǎng)#二十四節(jié)氣
2025-08-07 -
 告別“陡崗子”!高標(biāo)準(zhǔn)農(nóng)田讓農(nóng)機(jī)撒歡跑
2025-08-05
告別“陡崗子”!高標(biāo)準(zhǔn)農(nóng)田讓農(nóng)機(jī)撒歡跑
2025-08-05 -
 我來(lái)拍?你來(lái)拍!快來(lái)報(bào)名微短劇啦!
2025-08-02
我來(lái)拍?你來(lái)拍!快來(lái)報(bào)名微短劇啦!
2025-08-02









